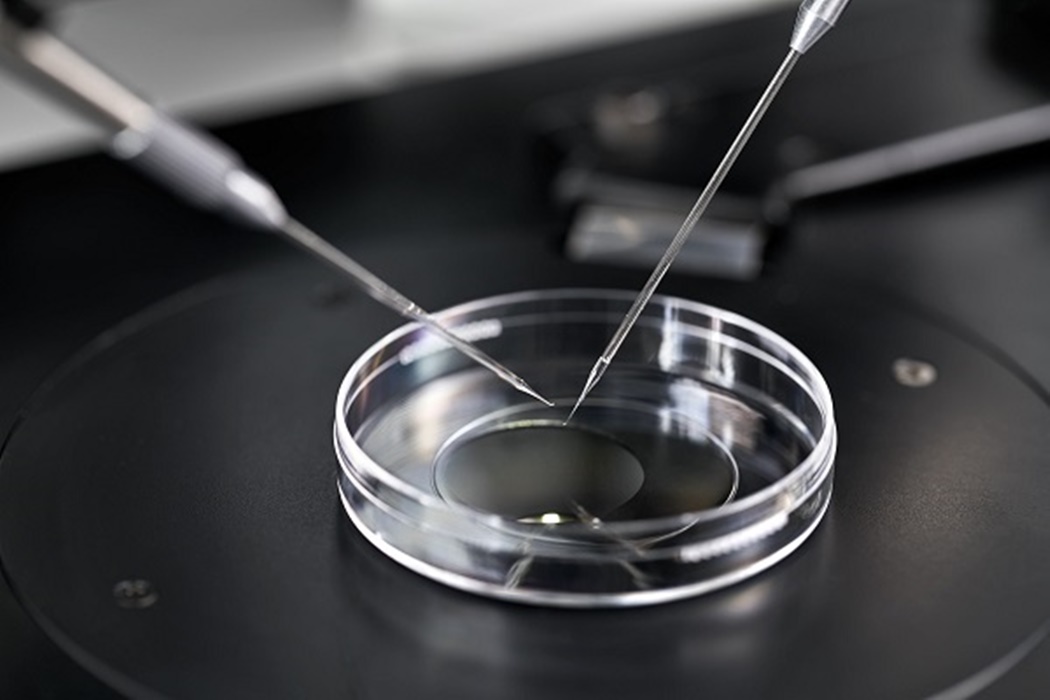
Process of in vitro fertilization in laboratory

Every couple’s fertility journey is different from the other, and some may have to turn to options such as In Vitro Fertilisation (IVF) when other methods have not yielded its intended results.
Reasons for couples seeking out IVF treatment include unexplained infertility, where there are no definite causes in patients, blockage in the left and right fallopian tubes which hinder the sperm from meeting the ovum, ovulatory dysfunction and even defects in sperm quality and quantity. However, with the procedure and childbearing process being so widely depicted in various mediums – in television shows, movies and even articles – the information on IVF tends to get rather convoluted and hence may present a rather distorted perception of what the actual procedure is like.
In conjunction with World IVF Day this year, Sunway Medical Centre Velocity’s (SMCV) Consultants would like to provide a holistic experience of what the IVF journey is actually like and provide clarity and reassurance for interested couples on what to take note of as fact and pay no mind to what is fiction.
1. IVF can be done at any age – Fiction

Dr Ashley Chung Soo Bee, Consultant Obstetrician and Gynaecologist from SMCV shares that the success rate of IVF is dependent on the patient’s age. “As their age advances, their ovarian reserve will decline – leading to deterioration in quality and quantity of eggs, hence the success rate of IVF decreases,” she shares. Thus, it is important for patients to receive medical consultation to determine if their health conditions are suitable for IVF before deciding to make it an option.
2. Patients who have gone through miscarriage cannot go through IVF – Fiction
With miscarriage being an emotionally distressing event for couples, it may be a challenge for them to try conceiving again for fear of having to experience it again.

However, Dr Farah Leong Rahman, Consultant Obstetrician and Gynaecologist from SMCV explains that IVF can be an option for such couples. “One of the major causes of miscarriage is an abnormal baby, and the patient’s body will deter it from implanting on the womb or result in a pregnancy loss.
By ensuring a healthy baby, the risk of miscarriage can be reduced.
After producing embryos by IVF, we can perform genetic tests on these future babies to check if there are healthy or not. Therefore, couples will have peace of mind knowing a healthy embryo will be transferred into the womb,” Dr Farah shares.
3. Patients do not need to worry about infertility if they already have a child – Fiction

Secondary infertility can occur in patients who have conceived before and may cause them to struggle to get pregnant with another child.
“Previous pregnancies may cause new fertility problems as a result of surgeries done in the previous pregnancy, surgery complications or infections following childbirth which may cause scarring, that can lead to infertility,” Dr Ashley says.
4. IVF is extremely expensive and out of reach for most – Fiction

Dr Farah explains that IVF in Malaysia is considerably much cheaper compared to other countries. She further elaborates that IVF comes with a high price tag as it requires many stages from stimulating the eggs in the ovaries through injections, egg retrieval once they are deemed optimal in size and the various procedures in the IVF lab that can only be carried out by skilled staff (embryologists) using specialised equipment.
This specialised equipment also costs a lot to buy, maintain and run to deliver the intended results. Fortunately, couples can rely on funding options such as EPF [1]for fertility treatments including IVF to help them on their journey.
5. IVF can cause early menopause – Fiction

While there are no absolute number of times one can go through IVF, Dr Farah reassures patients that the notion of IVF causing early menopause is simply not true. “During the process, we utilise eggs that are present in that particular month and even if not used, these eggs will be depleted before new ones are recruited the following month,” she says.
If the first cycle is unsuccessful, the consultants will look back at the patient’s cycles and see if there is anything that can be done differently this time to hopefully deliver better results.
Dr Farah adds, “Many couples are aware of IVF but more needs to be done in terms of fertility awareness. It is not easy for couples to step forward to seek help and talk about the challenges they face, but it is important to not delay screening or treatment as time is an essence. Always remember, you are not alone in this journey.”
Sunway Medical Centre Velocity is located at Lingkaran SV, Sunway Velocity. For enquiries, please contact +603 9772 9191 or email smcv-enquiry@sunway.com.my. For more information on Sunway Medical Centre Velocity, visit www.sunmedvelocity.com.my (Facebook: Sunway Medical Velocity).
[1] https://www.kwsp.gov.my/member/withdrawals/partial/health#Fertility_Treatment

